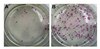

iPS
1480 Results
Advanced Search
Showing
Products (1,480)
Documents (0)
Site Content (0)
Narrow Your Results Use the filters below to refine your search
Products by Type
Key Applications
Product Brand
CAS #
Antibody Type
Analytes Available
Configuration
Format/Conjugation
Host
Kit or Assay Type
Pore Size (µm)
Species Reactivity
Volume, mL
Research Category
Gene Symbol
Compare
Select the checkbox on up to 4 items, then click compare for a detailed product comparison
SCM087 Sigma-AldrichMouse iPS Reprogramming Boost Supplement
The Mouse iPS Reprogramming Boost Supplement enhances the efficiency of mouse iPS colony formation by at least 3-fold.
SCM088 Sigma-AldrichHuman iPS Reprogramming Boost Supplement
The Human iPS Reprogramming Boost Supplement enhanced the efficiency of human iPS colony formation over ten-fold and reduced the time to establish full reprogrammed colonies by nearly 50%.
SCM094 Sigma-AldrichHuman iPS Reprogramming Boost Supplement II
EMD Millipore’s Human iPS Reprogramming Boost Supplement II contains three proprietary small molecules (TGF-β RI Kinase Inhibitor IV, Sodium Butyrate and PS48) and aids in somatic cell reprogramming by 10-15 fold.
SCM111 Sigma-AldrichHuman ES/iPS Neuronal Differentiation Medium
EMD Millipore’s Human ES/iPS Neuronal Differentiation Medium is a serum free/chemically defined optimized media for the rapid production of terminally differentiated neurons from human neural progenitor cells.
SCR502 Sigma-AldrichHuman, iPS Selection Kit
The Human iPS Selection Kit allows live cell imaging & identification of fully reprogrammed human induced pluripotent Stem cells from a heterogeneous population of reprogramming intermediates.
SCM110 Sigma-AldrichHuman ES/iPS Neural Induction Medium
EMD Millipore’s Human ES/iPS Neural Induction Mediium is an serum free/chemically defined optimized media for the rapid production of expandable neural progenitor cells from pluripotent human ES and iPS cells.
SCR603 Sigma-AldrichHuman ES/iPS Neurogenesis Kit
The human ES/iPS Neurogenesis Kit is a robust and user-friendly kit that contains the necessary serum free/chemically defined media and reagents for the rapid production of expandable neural progenitor cells and terminally differentiated neurons from pluripotent human ES/iPS cells
SCR077 Sigma-AldrichFluorescent Mouse ES/iPS Cell Characterization Kit
This Fluorescent Mouse ES/iPS Cell Characterization Kit contains a range of sensitive tools for the phenotypic assessment of the pluripotent status of mouse Embryonic stem & induced pluripotent Stem cells.
SCR078 Sigma-AldrichFluorescent Human ES/iPS Cell Characterization Kit
This Fluorescent Human ES/iPS Cell Characterization Kit contains a range of sensitive tools for the phenotypic assessment of the pluripotent status of human Embryonic stem & induced pluripotent Stem cells.
SCC271 Sigma-AldrichSimplicon® Human iPS Cell Line
Highly characterized integration-free human induced pluripotent stem cell (iPSC) line generated using Simplicon® RNA reprogramming technology.
Recommended Products
-

SCR078 Sigma-Aldrich Fluorescent Human ES/iPS Cell Characterization Kit -

SCC271 Sigma-Aldrich Simplicon® Human iPS Cell Line -
SCM087 Sigma-Aldrich Mouse iPS Reprogramming Boost Supplement -

SCM110 Sigma-Aldrich Human ES/iPS Neural Induction Medium -

71978 Sigma-Aldrich One Step RT-PCR Master Mix Kit -

SCC453 Sigma-Aldrich OSUMMER.9 Mouse NRAS-Mutant Melanoma Cell Line -

103789 Sucrose










